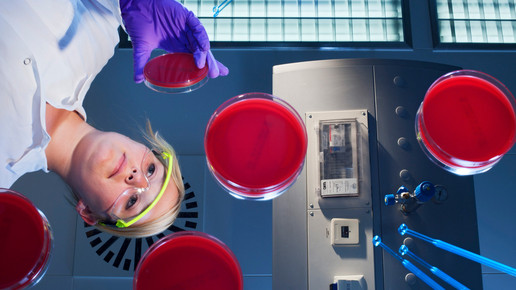

Urteil: Industrie ist apothekertypisch
Wer Pharmazie studiert, landet fast immer in der Apotheke: 80 Prozent der 62.000 Approbierten hierzulande arbeiten laut ABDA-Statistik in der Offizin; weitere 4 Prozent in der Krankenhausapotheke. Wer in der Industrie oder in der Verwaltung tätig ist, muss gegenüber der Deutschen Rentenversicherung (DRV) nachweisen, dass seine Aufgaben apothekertypisch sind. Ein aktuelles Urteil kommt zu dem Ergebnis, dass die Herstellung von Arzneimitteln auch heute noch zum Wesen des Apothekerberufs gehört.
Im Streit ging es um die Befreiung einer Apothekerin von der Rentenpflicht, die als Clinical Study Managerin arbeitet. Laut Stellenbeschreibung waren hierzu „ein Hochschulstudium im naturwissenschaftlichen Bereich sowie mindestens drei Jahre Erfahrung in der klinischen Forschung sowie die Befähigung zur Planung und Ausführung einer klinischen Studie aus operativer Sicht“ erforderlich.
Die DRV hatte argumentiert, dass aufgrund dieses Stellenprofils keinesfalls eine Approbation als Apotheker zwingend erforderlich sei. Die nachgereichte detaillierte Tätigkeitsbeschreibung stelle den Sachverhalt fehlerhaft und beschönigend dar.
In seinem Urteil kam das Sozialgericht München (SG) dagegen zu dem Schluss, dass fast alle mit Pharmazeuten besetzten Positionen in der Industrie auch dem Berufsbild eines Apothekers entsprechen. Nur im Ausnahmefall sei dies nicht so.
Grundsätzlich sei es naheliegend, dass Apotheker in der pharmazeutischen Industrie berufstypische Tätigkeiten ausführten: „Denn die apothekerliche Aufgabe der Medikamentenentwicklung beziehungsweise -herstellung findet heutzutage nicht mehr in der öffentlichen Apotheke, sondern primär in den Kliniken im engen Verbund mit der pharmazeutischen Industrie statt“, heißt es in dem Urteil.
Mit der engen Auslegung der Vorschriften zur Befreiung von der Rentenversicherungspflicht haben die Richter ein Problem: „Da die Approbation im Bereich der pharmazeutischen Industrie als Berufszugangsbedingung von Gesetz wegen nicht existiert, führte der missverständliche Ausdruck der 'zwingend erforderlichen Approbation' dazu, dass nur noch Tätigkeiten im Bereich der öffentlichen und Krankenhausapotheken, für den die Approbation vorausgesetzt wird, nicht aber für Tätigkeiten im pharmazeutisch-industriellen Komplex befreit werden könnte.“
Im Verfahren hatte die DRV argumentiert, dass in der Industrie auch andere akademische Berufe vertreten sind, beispielsweise Chemiker und Biochemiker. So gesehen könne auf Pharmazeuten sogar komplett verzichtet werden. Das sahen die Richter komplett anders: „Mit der gleichen Argumentation ließe sich vertreten, dass die Tätigkeit eines Chemikers in der chemischen Industrie nicht berufsspezifisch sei.“
Besonders augenfällig sei die Nähe zur Pharmazie, da laut Arzneimittelgesetz (AMG) andere Akademiker wie Chemiker, Biologen oder Mediziner erst eine an die Approbation angelehnte Zusatzausbildung oder -prüfung ablegen müssten. Konkret genannt werden unter anderem die Fächer Pharmazeutische Chemie, Pharmakologie, Pharmazeutische Technologie und Pharmazeutische Biologie. Dies zeigt den Richtern zufolge, dass „apothekerliche Kenntnisse nicht 'am Rande' (noch) mit verwendet werden, sondern gesetzlich vorgesehener Kernbestand“ sind.
Ein Blick in die Approbationsordnung zeige, dass das Pharmaziestudium interdisziplinär angelegt sei, sodass eine Zusammenarbeit mit anderen Disziplinen bei der Entwicklung, Herstellung und Prüfung von Medikamenten im apothekerlichen Berufsbild angelegt sei und daher nicht gegen das Vorliegen einer apothekertypischen Tätigkeit verwendet werden dürfe.
Als Clinical Study Manager war die Apothekerin unter anderem für die Vorbereitung und Durchführung onkologischer Studien verantwortlich. Dazu gehörten die umfassende Aufklärung der Patienten über mutmaßliche Wirkungen und Risiken, die Überwachung sämtlicher operativer Maßnahmen und die Einhaltung der Prüfbedingungen.
Gerade für diese Tätigkeiten ist laut Gericht die Ausbildung als Apothekerin „unabdingbare Voraussetzung“, da die Substanzen bis hin zur Lagerbarkeit noch nicht optimiert sind. So gesehen komme es auf das Verständnis für die Veränderung von Medikamenten an, insbesondere was das Wechselspiel von Wirk- und Hilfssubstanzen an.
Diese Aufgabe als nicht apothekerlich zu erachten, ist laut Urteil „realitätsfern“ und nicht zu vereinbaren mit der Berufsordnung, in der Tätigkeiten in der Industrie aufgeführt sind. Die Apothekerkammer hatte ihr die apothekerliche Tätigkeit bescheinigt.
Die vertragliche Stellenbeschreibung habe gegenüber dem detaillierten Tätigkeitsprofil nur eine untergeordnete Bedeutung, da sie „von einem internationalen Konzern aus globaler Sicht ohne hinreichende Berücksichtigung der Aufgabe 'vor Ort' angefertigt wurde“.
Erschwerend hinzu kam, dass die DRV nur ein Jahr zuvor noch einem Antrag der Apothekerin auf Befreiung von der gesetzlichen Rentenversicherung zugestimmt hatte – für die Richter vollkommen unverständlich: Zwar habe ein Jobwechsel stattgefunden, doch die beiden Tätigkeitsprofile seien sich sehr ähnlich.
Bereits vor einigen Jahren mussten sich eine Vielzahl von Apothekern, die in der Industrie tätig waren, mit der DRV um ihre Befreiung streiten. Im September 2012 einigten sich die Prüfer mit der Arbeitsgemeinschaft Berufsständischer Versorgungseinrichtungen (ABV): Apotheker, die außerhalb der Apotheke arbeiten, müssen dem Antrag zur Befreiung von der Rentenversicherungspflicht seitdem bei jedem Jobwechsel eine Stellen- und Funktionsbeschreibung beifügen.
Laut ABV sind beispielsweise Drug Safety Officer und andere wissenschaftlich nahe Tätigkeiten, die nur von Apothekern, Ärzten und Tierärzten ausgeübt werden können, befreiungsfähig. Schwierig sei es für Pharmareferenten und Pharmaberater, da hier die kaufmännische Tätigkeit im Vordergrund stehe.

APOTHEKE ADHOC Debatte